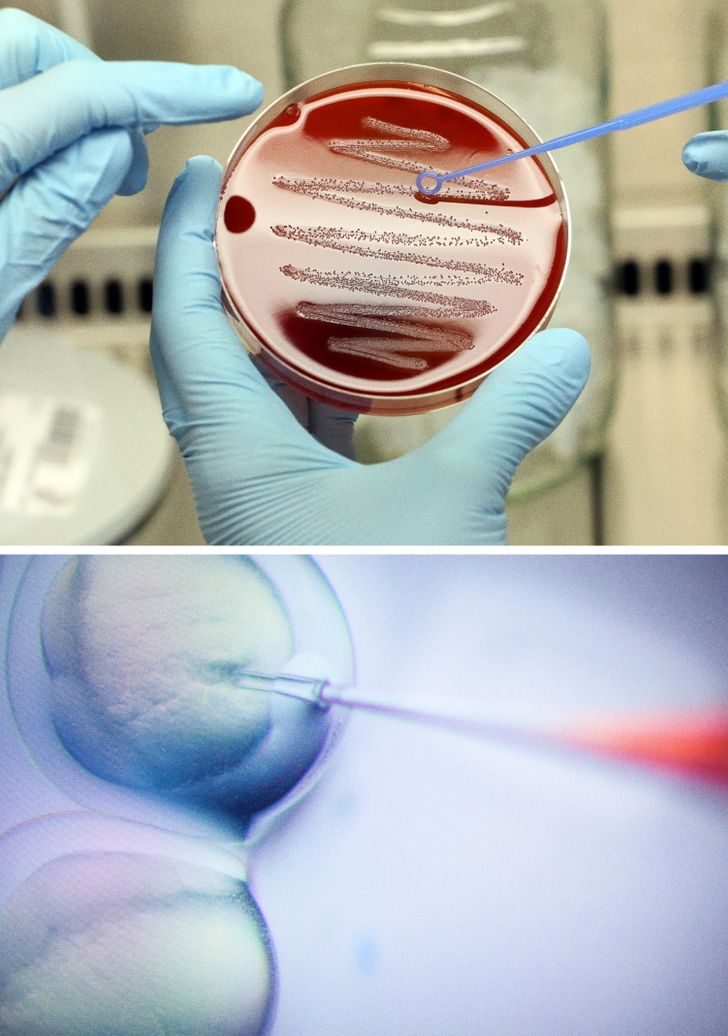

7 фактов о человеке, которые не спешат раскрывать антропологи
Северус Снейп говорил, что у Гарри Поттера мамины глаза и невыносимый папин характер. Если бы профессор копнул глубже, то обнаружил бы у ученика жабры и хвост, доставшиеся ему от совсем далеких предков. Не сомневайтесь, такое наследство есть у каждого из нас.

Американские ученые сравнили ДНК людей из семей долгожителей и тех, у предков которых продолжительность жизни средняя и низкая. Выяснилось, что у членов семьи долгожителей гораздо меньше вредных генов, в первую очередь связанных с болезнью Альцгеймера, предрасположенностью к курению, лишнему весу, астме и атеросклерозу. То есть эволюция пытается сократить количество носителей плохой генетики.
А ученые из европейских вузов предположили, что сейчас роль естественного отбора выросла. Дело в том, что люди чаще всего выбирают партнеров для продолжения рода вне зависимости от социального статуса и таким образом дают генам больше возможностей для сочетания.

Наши челюсти, гортань, хрящи трахеи, часть среднего уха, миндалины, диафрагма и дыхательная мускулатура — все это развилось из жабр. Благодаря им мы дышим, слышим, глотаем и говорим.
У некоторых людей есть небольшая дырочка на верхней части уха (или обоих ушей). По мнениюбиолога Нила Шубина, это отверстие может быть остатком жабр.

За последние 25 000 лет средний объем человеческого мозга уменьшился с 1 500 куб. см до 1350. Одной из причин этого может быть снижение интеллекта. Древние люди жили в гораздо более сложных условиях. Они должны были держать в памяти всю имеющуюся информацию об окружающем мире и владеть максимальным количеством доступных навыков, чтобы выжить. Сегодня нам даже не обязательно знать, как готовить пищу, а уж запоминать тонны информации и вовсе нет нужды: она есть в интернете и в книгах.

Американские антропологи пришли к выводу, что челюсть человека уменьшилась после того, как люди одомашнили коз и в рационе появились молочные продукты, которые не требуют тщательного пережевывания. Однако это произошло слишком быстро, и количество зубов не успело подстроиться под новую форму человеческого лица. Поэтому зубы мудрости часто доставляют нам дискомфорт: им просто тесно у нас во рту, и они растут неправильно.

Прежде чем съесть пищу, паук обволакивает ее слюной, чтобы расщепить белки, и только потом проглатывает получившуюся кашицу. С точки зрения биологии человек делает что-то подобное, когда варит суп.

Ученые научились редактировать человеческие гены для лечения некоторых форм рака. Следующим логическим шагом будет изменение генов в эмбрионах человека, считаетпреподаватель эволюционной биологии Скотт Соломон. Отредактированные гены будут переданы последующим поколениям. И как только это произойдет, мы станем первым видом в истории, способным управлять собственной эволюцией.
Естественный отбор продолжается

Американские ученые сравнили ДНК людей из семей долгожителей и тех, у предков которых продолжительность жизни средняя и низкая. Выяснилось, что у членов семьи долгожителей гораздо меньше вредных генов, в первую очередь связанных с болезнью Альцгеймера, предрасположенностью к курению, лишнему весу, астме и атеросклерозу. То есть эволюция пытается сократить количество носителей плохой генетики.
А ученые из европейских вузов предположили, что сейчас роль естественного отбора выросла. Дело в том, что люди чаще всего выбирают партнеров для продолжения рода вне зависимости от социального статуса и таким образом дают генам больше возможностей для сочетания.
Человек по пояс состоит из жабр

Наши челюсти, гортань, хрящи трахеи, часть среднего уха, миндалины, диафрагма и дыхательная мускулатура — все это развилось из жабр. Благодаря им мы дышим, слышим, глотаем и говорим.
У некоторых людей есть небольшая дырочка на верхней части уха (или обоих ушей). По мнениюбиолога Нила Шубина, это отверстие может быть остатком жабр.
Наши предки были не глупее, а возможно, даже умнее нас

За последние 25 000 лет средний объем человеческого мозга уменьшился с 1 500 куб. см до 1350. Одной из причин этого может быть снижение интеллекта. Древние люди жили в гораздо более сложных условиях. Они должны были держать в памяти всю имеющуюся информацию об окружающем мире и владеть максимальным количеством доступных навыков, чтобы выжить. Сегодня нам даже не обязательно знать, как готовить пищу, а уж запоминать тонны информации и вовсе нет нужды: она есть в интернете и в книгах.
На эволюцию человека влияют каноны красоты
В середине XVIII века средний рост голландских солдат составлял 165 см, они были значительно ниже, чем представители других европейских стран. Но за 150 лет мужчины из Нидерландов выросли на 20 см и вошли в число самых высоких в мире. Ученые пришли к выводу, что это связано со вкусом голландских женщин. Они находят высоких мужчин привлекательнее и чаще заключают с ними браки. Поэтому у рослых голландцев, согласно исследованию, детей больше, чем у их соотечественников ростом ниже.Болезни зубов мудрости — результат эволюции

Американские антропологи пришли к выводу, что челюсть человека уменьшилась после того, как люди одомашнили коз и в рационе появились молочные продукты, которые не требуют тщательного пережевывания. Однако это произошло слишком быстро, и количество зубов не успело подстроиться под новую форму человеческого лица. Поэтому зубы мудрости часто доставляют нам дискомфорт: им просто тесно у нас во рту, и они растут неправильно.
Кулинария — это часть пищеварения. Как у паука

Прежде чем съесть пищу, паук обволакивает ее слюной, чтобы расщепить белки, и только потом проглатывает получившуюся кашицу. С точки зрения биологии человек делает что-то подобное, когда варит суп.
Человек будет сам направлять свою эволюцию
Ученые научились редактировать человеческие гены для лечения некоторых форм рака. Следующим логическим шагом будет изменение генов в эмбрионах человека, считаетпреподаватель эволюционной биологии Скотт Соломон. Отредактированные гены будут переданы последующим поколениям. И как только это произойдет, мы станем первым видом в истории, способным управлять собственной эволюцией.
Только зарегистрированные и авторизованные пользователи могут оставлять комментарии.
0
красота — дамская привилегия. сейчас дамы предпочитают умных мужчин.
- ↓
-3
фу какая фуйня… нах я сюда влез…
- ↓
Комментарий удалён за нарушение

